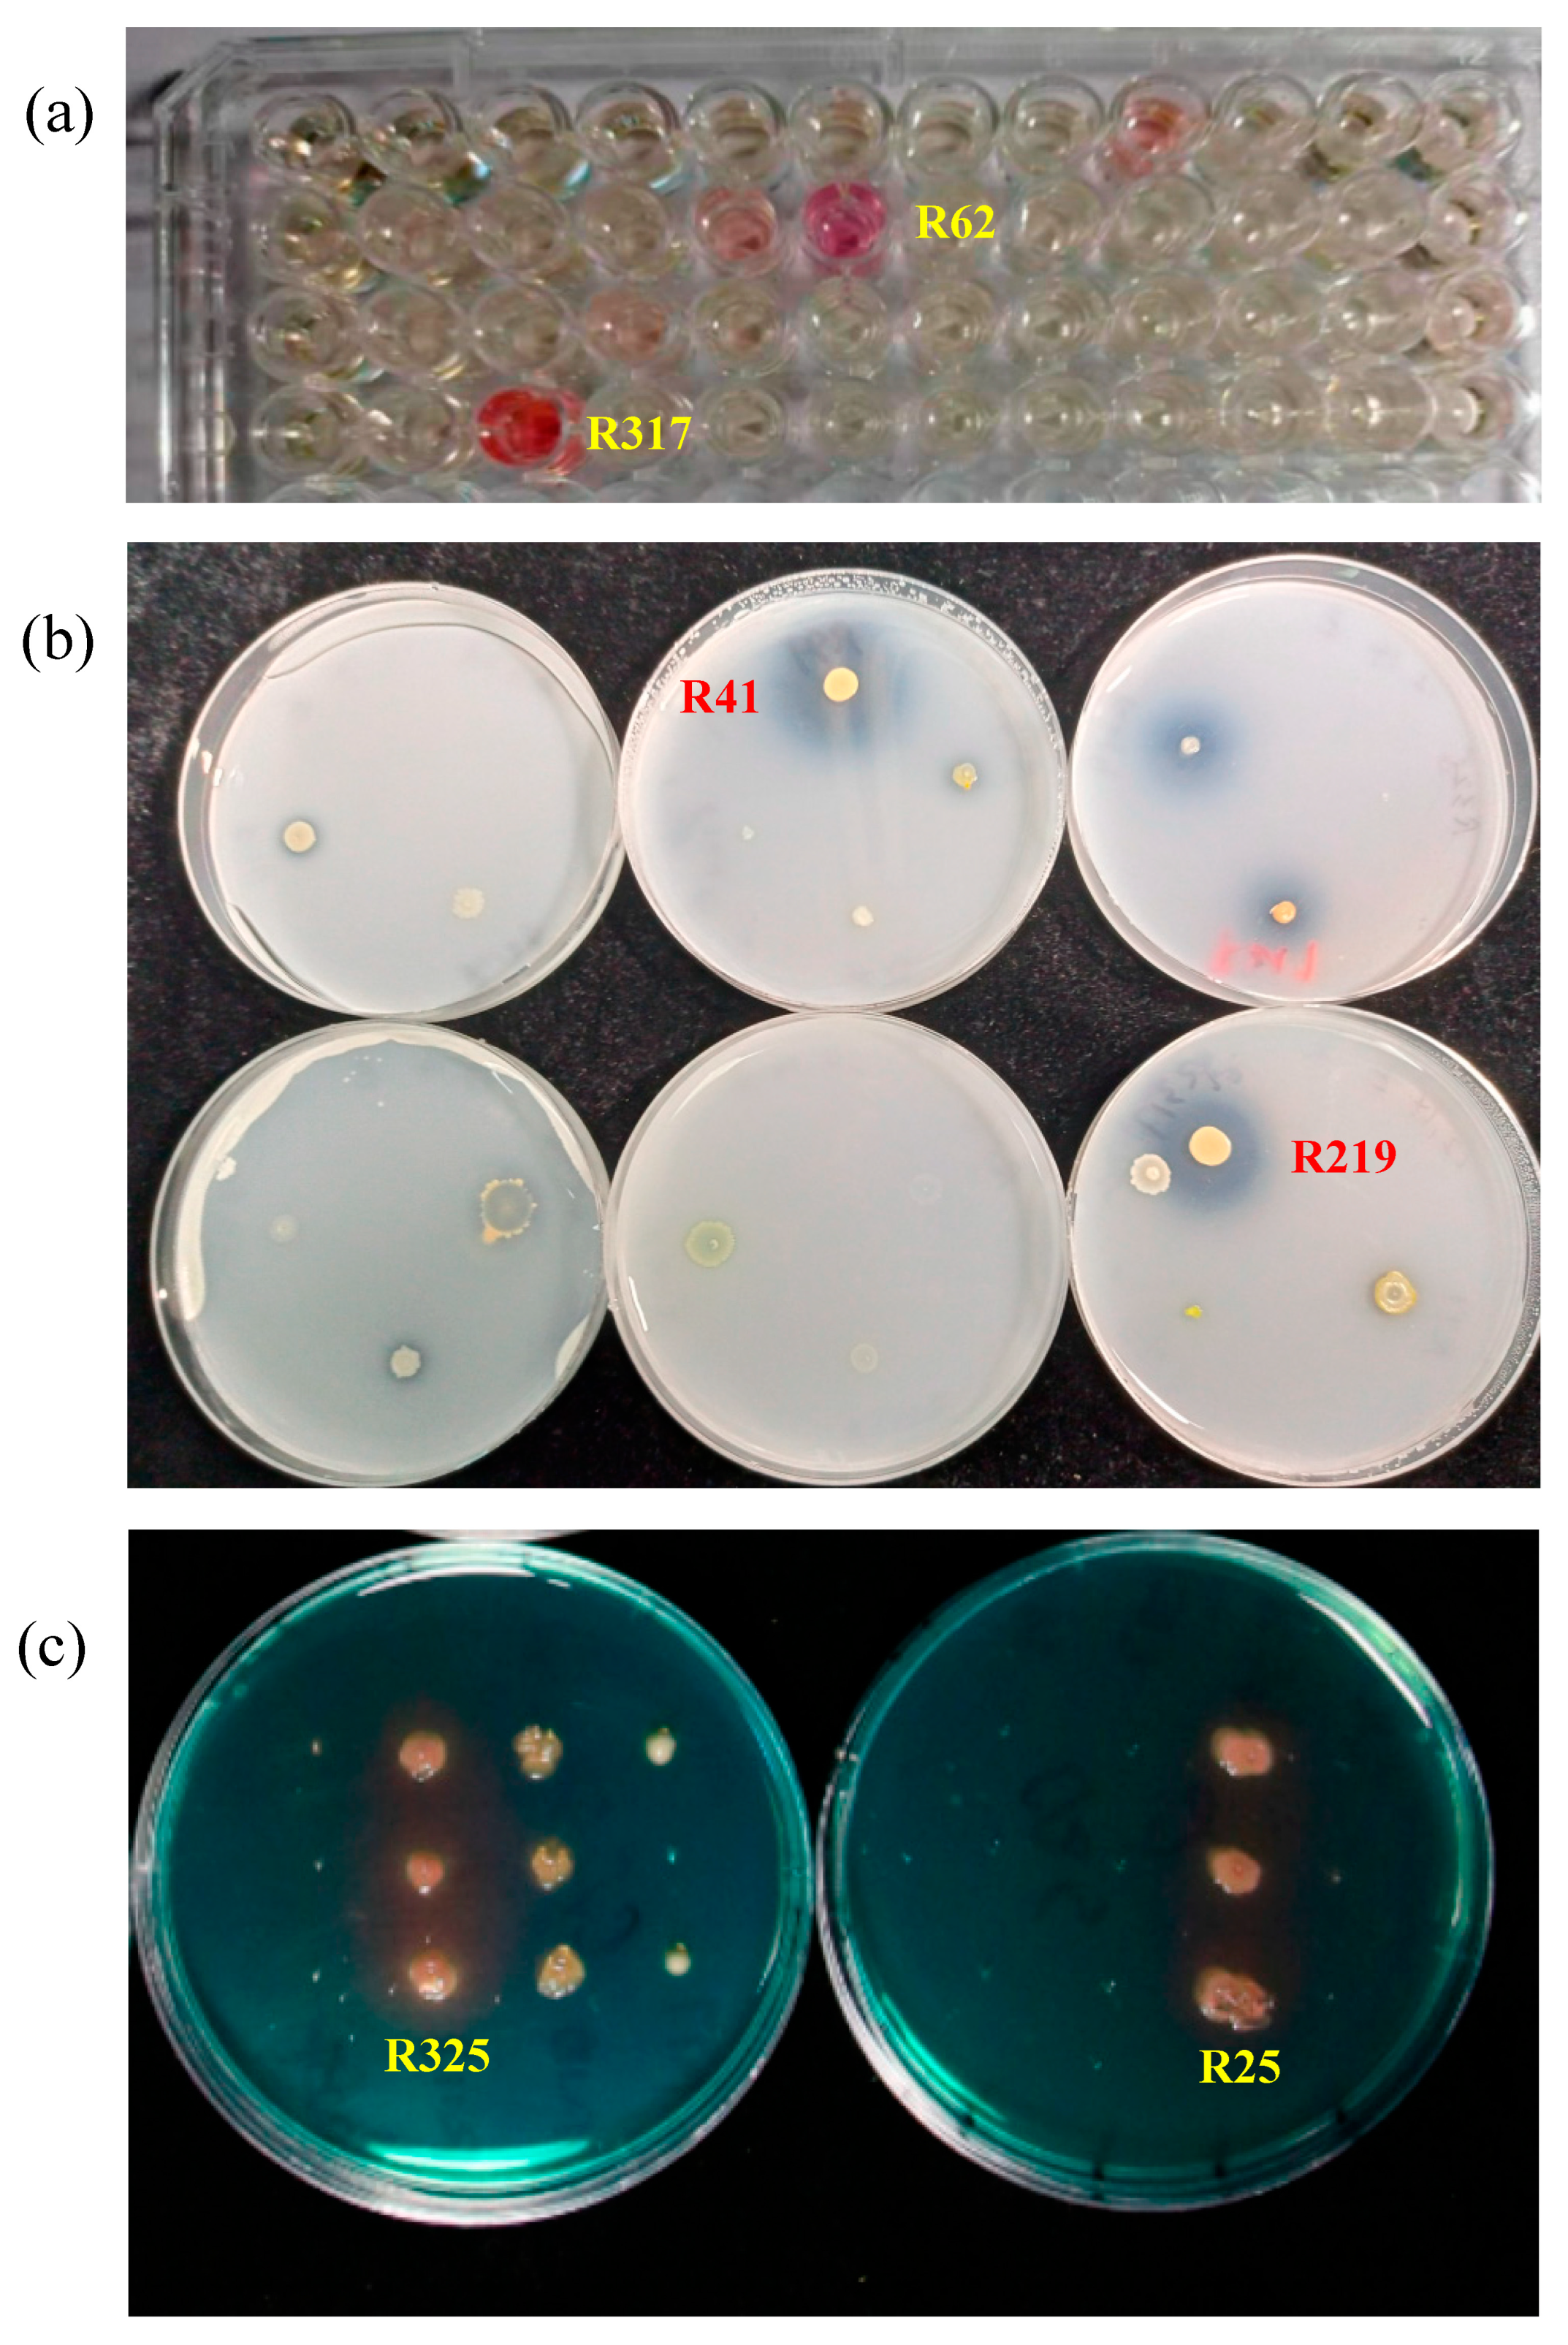
Plants 12 04000 g001

Assembly of Tomato Rhizobacteria from Different Functional Groups Improves Seedling Photosynthesis and Growth
Abstract
:1. Introduction
2. Results
2.1. The Selected Strains Show Traits Beneficial for Plant Growth
2.2. Effect of Bacterial Combinations on the Growth of Tomato Seedlings
2.3. Effect of Bacterial Inoculation on Photosynthetic Parameters
2.4. Effect of Bacterial Inoculation on the Expression of Genes Involved in Photosynthetic Carbon Assimilation
2.5. Effect of Bacterial Inoculation on Defense Related Enzymes
2.6. Effect of Bacterial Inoculation on Seed Germination of Tomato
3. Material and Methods
3.1. Bacterial Strains Used for the Studies
3.2. Identification of Bacterial Strains
3.3. Analysis of Plant-Growth Promotion Traits
3.4. Tomato and Soil Materials Used in the Experiment
3.5. Pot Inoculation and Analysis of Growth Indicators
3.6. Determination of Photosynthetic Parameters
3.7. Detection of Expression Levels of Genes Involved in Photosynthetic Carbon Assimilation
3.8. Assay of Activities of PPO and POD
3.9. Stimulatory Effect on Seed Germination of Tomato
3.10. Data Analysis
4. Discussion
4.1. The Bacterial Combinations Have a More Pronounced Growth-Promoting Effect on Tomato Seedlings Compared to a Single Bacterium
4.2. The Bacterial Combinations Can Enhance the Photosynthetic Capacity of Tomato Seedlings
4.3. The Bacterial Combinations Potentially Improve the Resistance of Tomato Plants to Stresses
4.4. The Bacterial Combinations Soaking Seeds Can Increase Seed Vigor
Supplementary Materials
Author Contributions
Funding
Data Availability Statement
Conflicts of Interest
References
- Ristaino, J.B.; Anderson, P.K.; Bebber, D.P.; Brauman, K.A.; Cunniffe, N.J.; Fedoroff, N.V.; Finegold, C.; Garrett, K.A.; Gilligan, C.A.; Jones, C.M.; et al. The Persistent Threat of Emerging Plant Disease Pandemics to Global Food Security. Proc. Natl. Acad. Sci. USA 2021, 118, e2022239118. [Google Scholar] [CrossRef]
- Alfosea-Simón, M.; Simón-Grao, S.; Zavala-Gonzalez, E.A.; Cámara-Zapata, J.M.; Simón, I.; Martínez-Nicolás, J.J.; Lidón, V.; Rodríguez-Ortega, W.M.; García-Sánchez, F. Application of Biostimulants Containing Amino Acids to Tomatoes Could Favor Sustainable Cultivation: Implications for Tyrosine, Lysine, and Methionine. Sustainability 2020, 12, 9729. [Google Scholar] [CrossRef]
- Lal, R. Restoring Soil Quality to Mitigate Soil Degradation. Sustainability 2015, 7, 5875–5895. [Google Scholar] [CrossRef]
- Przygocka-Cyna, K.; Biber, M.; Przygocka-Cyna, K.; Grzebisz, W. Evaluation of the Potential of Bio-Fertilizers as a Source of Nutrients and Heavy Metals by Means of the Exhaustion Lettuce Test. J. Elem. 2018, 23, 429–445. [Google Scholar] [CrossRef]
- Lai, J.; Wang, X. Plant Diseases and Pests Detection Based on Deep Learning: A Review. Plant Methods 2021, 17, 22. [Google Scholar] [CrossRef]
- Song, Q.; Fu, H.; Shi, Q.; Shan, X.; Wang, Z.; Sun, Z.; Li, T. Overfertilization Reduces Tomato Yield under Long-Term Continuous Cropping System via Regulation of Soil Microbial Community Composition. Front. Microbiol. 2022, 13, 952021. [Google Scholar] [CrossRef]
- Cheng, F.; Ali, M.; Liu, C.; Deng, R.; Cheng, Z. Garlic Allelochemical Diallyl Disulfide Alleviates Autotoxicity in the Root Exudates Caused by Long-Term Continuous Cropping of Tomato. J. Agric. Food Chem. 2020, 68, 11684–11693. [Google Scholar] [CrossRef] [PubMed]
- Lynch, J.M.; Brimecombe, M.J.; Leij, F.A. Rhizosphere. In eLS; John Wiley & Sons, Ltd., Ed.; Wiley: Hoboken, NJ, USA, 2001; ISBN 978-0-470-01617-6. [Google Scholar]
- Adedayo, A.A.; Babalola, O.O.; Prigent-Combaret, C.; Cruz, C.; Stefan, M.; Kutu, F.; Glick, B.R. The Application of Plant Growth-Promoting Rhizobacteria in Solanum lycopersicum Production in the Agricultural System: A Review. PeerJ 2022, 10, e13405. [Google Scholar] [CrossRef]
- Basu, A.; Prasad, P.; Das, S.N.; Kalam, S.; Sayyed, R.Z.; Reddy, M.S.; El Enshasy, H. Plant Growth Promoting Rhizobacteria (PGPR) as Green Bioinoculants: Recent Developments, Constraints, and Prospects. Sustainability 2021, 13, 1140. [Google Scholar] [CrossRef]
- Granada, C.E.; Passaglia, L.M.P.; De Souza, E.M.; Sperotto, R.A. Is Phosphate Solubilization the Forgotten Child of Plant Growth-Promoting Rhizobacteria? Front. Microbiol. 2018, 9, 2054. [Google Scholar] [CrossRef]
- Zaidi, A.; Khan, M.S.; Saif, S.; Rizvi, A.; Ahmed, B.; Shahid, M. Role of Nitrogen-Fixing Plant Growth-Promoting Rhizobacteria in Sustainable Production of Vegetables: Current Perspective. In Microbial Strategies for Vegetable Production; Zaidi, A., Khan, M.S., Eds.; Springer International Publishing: Cham, Switzerland, 2017; pp. 49–79. ISBN 978-3-319-54400-7. [Google Scholar]
- Tsukanova, K.A.; Chebotar, V.K.; Meyer, J.J.M.; Bibikova, T.N. Effect of Plant Growth-Promoting Rhizobacteria on Plant Hormone Homeostasis. S. Afr. J. Bot. 2017, 113, 91–102. [Google Scholar] [CrossRef]
- Moore, J.A.M.; Abraham, P.E.; Michener, J.K.; Muchero, W.; Cregger, M.A. Ecosystem Consequences of Introducing Plant Growth Promoting Rhizobacteria to Managed Systems and Potential Legacy Effects. New Phytol. 2022, 234, 1914–1918. [Google Scholar] [CrossRef]
- Seneviratne, G.; Weerasekara, M.L.M.A.W.; Seneviratne, K.A.C.N.; Zavahir, J.S.; Kecskés, M.L.; Kennedy, I.R. Importance of Biofilm Formation in Plant Growth Promoting Rhizobacterial Action. In Plant Growth and Health Promoting Bacteria; Maheshwari, D.K., Ed.; Microbiology Monographs; Springer: Berlin/Heidelberg, Germany, 2010; Volume 18, pp. 81–95. ISBN 978-3-642-13611-5. [Google Scholar]
- Ramamoorthy, V.; Viswanathan, R.; Raguchander, T.; Prakasam, V.; Samiyappan, R. Induction of Systemic Resistance by Plant Growth Promoting Rhizobacteria in Crop Plants against Pests and Diseases. Crop Prot. 2001, 20, 1–11. [Google Scholar] [CrossRef]
- Herschkovitz, Y.; Lerner, A.; Davidov, Y.; Rothballer, M.; Hartmann, A.; Okon, Y.; Jurkevitch, E. Inoculation with the Plant-Growth-Promoting Rhizobacterium Azospirillum Brasilense Causes Little Disturbance in the Rhizosphere and Rhizoplane of Maize (Zea mays). Microb. Ecol. 2005, 50, 277–288. [Google Scholar] [CrossRef]
- Nakkeeran, S.; Fernando, W.G.D.; Siddiqui, Z.A. Plant Growth Promoting Rhizobacteria Formulations and Its Scope in Commercialization for the Management of Pests and Diseases. In PGPR: Biocontrol and Biofertilization; Siddiqui, Z.A., Ed.; Springer: Berlin/Heidelberg, Germany, 2006; pp. 257–296. ISBN 978-1-4020-4002-3. [Google Scholar]
- Khalid, A.; Arshad, M.; Shaharoona, B.; Mahmood, T. Plant Growth Promoting Rhizobacteria and Sustainable Agriculture. In Microbial Strategies for Crop Improvement; Khan, M.S., Zaidi, A., Musarrat, J., Eds.; Springer: Berlin, Heidelberg, Germany, 2009; pp. 133–160. ISBN 978-3-642-01978-4. [Google Scholar]
- Roberts, D.; Mattoo, A. Sustainable Agriculture—Enhancing Environmental Benefits, Food Nutritional Quality and Building Crop Resilience to Abiotic and Biotic Stresses. Agriculture 2018, 8, 8. [Google Scholar] [CrossRef]
- Somasegaran, P.; Hoben, H.J. Isolating and Purifying Genomic DNA of Rhizobia Using a Large-Scale Method. In Handbook for Rhizobia; Springer: New York, NY, USA, 1994; pp. 279–283. ISBN 978-1-4613-8377-2. [Google Scholar]
- Edwards, U.; Rogall, T.; Blöcker, H.; Emde, M.; Böttger, E.C. Isolation and Direct Complete Nucleotide Determination of Entire Genes. Characterization of a Gene Coding for 16S Ribosomal RNA. Nucl. Acids Res. 1989, 17, 7843–7853. [Google Scholar] [CrossRef]
- Murphy, J.; Riley, J.P. A Modified Single Solution Method for the Determination of Phosphate in Natural Waters. Anal. Chim. Acta 1962, 27, 31–36. [Google Scholar] [CrossRef]
- Gordon, S.A.; Weber, R.P. Colorimetric estimation of indoleacetic acid. Plant Physiol. 1951, 26, 192–195. [Google Scholar] [CrossRef] [PubMed]
- Louden, B.C.; Haarmann, D.; Lynne, A.M. Use of Blue Agar CAS Assay for Siderophore Detection. J. Microbiol. Biol. Educ. 2011, 12, 51–53. [Google Scholar] [CrossRef] [PubMed]
- Srivastava, M.P.; Gupta, S.; Sharma, Y.K. Detection of Siderophore Production from Different Cultural Variables by CAS-Agar Plate Assay. Asian J. Pharm. Pharmacol. 2018, 4, 66–69. [Google Scholar] [CrossRef]
- Manai, J.; Kalai, T.; Gouia, H.; Corpas, F.J. Exogenous Nitric Oxide (NO) Ameliorates Salinity-Induced Oxidative Stress in Tomato (Solanum lycopersicum) Plants. J. Soil Sci. Plant Nutr. 2014, 14, 433–446. [Google Scholar] [CrossRef]
- Chakraborty, N.; Ghosh, S.; Chandra, S.; Sengupta, S.; Acharya, K. Abiotic Elicitors Mediated Elicitation of Innate Immunity in Tomato: An Ex Vivo Comparison. Physiol. Mol. Biol. Plants 2016, 22, 307–320. [Google Scholar] [CrossRef]
- Patra, J.K. Microbial Biotechnology: Volume 1. Applications in Agriculture and Environment; Springer: New York, NY, USA, 2017; ISBN 978-981-10-6846-1. [Google Scholar]
- Keeler, B.L.; Gourevitch, J.D.; Polasky, S.; Isbell, F.; Tessum, C.W.; Hill, J.D.; Marshall, J.D. The Social Costs of Nitrogen. Sci. Adv. 2016, 2, e1600219. [Google Scholar] [CrossRef] [PubMed]
- Rodríguez-Caballero, E.; Castro, A.J.; Chamizo, S.; Quintas-Soriano, C.; Garcia-Llorente, M.; Cantón, Y.; Weber, B. Ecosystem Services Provided by Biocrusts: From Ecosystem Functions to Social Values. J. Arid. Environ. 2018, 159, 45–53. [Google Scholar] [CrossRef]
- Rolli, E.; Marasco, R.; Vigani, G.; Ettoumi, B.; Mapelli, F.; Deangelis, M.L.; Gandolfi, C.; Casati, E.; Previtali, F.; Gerbino, R.; et al. Improved Plant Resistance to Drought Is Promoted by the Root-Associated Microbiome as a Water Stress-Dependent Trait: Root Bacteria Protect Plants from Drought. Environ. Microbiol. 2015, 17, 316–331. [Google Scholar] [CrossRef] [PubMed]
- Molina-Romero, D.; Baez, A.; Quintero-Hernández, V.; Castañeda-Lucio, M.; Fuentes-Ramírez, L.E.; Bustillos-Cristales, M.D.R.; Rodríguez-Andrade, O.; Morales-García, Y.E.; Munive, A.; Muñoz-Rojas, J. Compatible Bacterial Mixture, Tolerant to Desiccation, Improves Maize Plant Growth. PLoS ONE 2017, 12, e0187913. [Google Scholar] [CrossRef] [PubMed]
- Berendsen, R.L.; Vismans, G.; Yu, K.; Song, Y.; De Jonge, R.; Burgman, W.P.; Burmølle, M.; Herschend, J.; Bakker, P.A.H.M.; Pieterse, C.M.J. Disease-Induced Assemblage of a Plant-Beneficial Bacterial Consortium. ISME J. 2018, 12, 1496–1507. [Google Scholar] [CrossRef]
- Berg, M.; Koskella, B. Nutrient- and Dose-Dependent Microbiome-Mediated Protection against a Plant Pathogen. Curr. Biol. 2018, 28, 2487–2492.e3. [Google Scholar] [CrossRef]
- De Vrieze, M.; Germanier, F.; Vuille, N.; Weisskopf, L. Combining Different Potato-Associated Pseudomonas Strains for Improved Biocontrol of Phytophthora Infestans. Front. Microbiol. 2018, 9, 2573. [Google Scholar] [CrossRef]
- Rivett, D.W.; Jones, M.L.; Ramoneda, J.; Mombrikotb, S.B.; Ransome, E.; Bell, T. Elevated Success of Multispecies Bacterial Invasions Impacts Community Composition during Ecological Succession. Ecol. Lett. 2018, 21, 516–524. [Google Scholar] [CrossRef]
- Backer, R.; Rokem, J.S.; Ilangumaran, G.; Lamont, J.; Praslickova, D.; Ricci, E.; Subramanian, S.; Smith, D.L. Plant Growth-Promoting Rhizobacteria: Context, Mechanisms of Action, and Roadmap to Commercialization of Biostimulants for Sustainable Agriculture. Front. Plant Sci. 2018, 9, 1473. [Google Scholar] [CrossRef]
- Shahab, S.; Ahmed, N.; Khan, N.S. Indole Acetic Acid Production and Enhanced Plant Growth Promotion by Indigenous PSBs. Afr. J. Agric. Res. 2009, 4, 1312–1316. [Google Scholar]
- Dashti, N.H.; Al-Sarraf, N.Y.A.; Cherian, V.M.; Montasser, M.S. Isolation and Characterization of Novel Plant Growth-Promoting Rhizobacteria (PGPR) Isolates from Tomato (Solanum lycopersicum L.) Rhizospherical Soil: A Novel IAA Producing Bacteria. Kuwait J. Sci. 2021, 48. [Google Scholar] [CrossRef]
- Ahemad, M.; Khan, M.S. Ameliorative Effects of Mesorhizobium Sp. MRC4 on Chickpea Yield and Yield Components under Different Doses of Herbicide Stress. Pestic. Biochem. Physiol. 2010, 98, 183–190. [Google Scholar] [CrossRef]
- Ahmed, E.; Holmström, S.J.M. Siderophores in Environmental Research: Roles and Applications: Siderophores in Environmental Research. Microb. Biotechnol. 2014, 7, 196–208. [Google Scholar] [CrossRef]
- Sundaram, L.; Rajendran, S.; Subramanian, N. Metal Stress Impacting Plant Growth in Contaminated Soil Is Alleviated by Microbial Siderophores. In Role of Microbial Communities for Sustainability; Seneviratne, G., Zavahir, J.S., Eds.; Microorganisms for Sustainability; Springer: Singapore, 2021; Volume 29, pp. 317–332. ISBN 9789811599118. [Google Scholar]
- Vorholt, J.A.; Vogel, C.; Carlström, C.I.; Müller, D.B. Establishing Causality: Opportunities of Synthetic Communities for Plant Microbiome Research. Cell Host Microbe 2017, 22, 142–155. [Google Scholar] [CrossRef]
- Gai, Z.; Zhang, M.; Zhang, P.; Zhang, J.; Liu, J.; Cai, L.; Yang, X.; Zhang, N.; Yan, Z.; Liu, L.; et al. 2-Oxoglutarate Contributes to the Effect of Foliar Nitrogen on Enhancing Drought Tolerance during Flowering and Grain Yield of Soybean. Sci. Rep. 2023, 13, 7274. [Google Scholar] [CrossRef] [PubMed]
- Sun, J.; Sui, X.; Wang, S.; Wei, Y.; Huang, H.; Hu, L.; Zhang, Z. The Response of rbcL, rbcS and Rca Genes in Cucumber (Cucumis sativus L.) to Growth and Induction Light Intensity. Acta Physiol. Plant. 2014, 36, 2779–2791. [Google Scholar] [CrossRef]
- Martin-Avila, E.; Lim, Y.-L.; Birch, R.; Dirk, L.M.A.; Buck, S.; Rhodes, T.; Sharwood, R.E.; Kapralov, M.V.; Whitney, S.M. Modifying Plant Photosynthesis and Growth via Simultaneous Chloroplast Transformation of Rubisco Large and Small Subunits. Plant Cell 2020, 32, 2898–2916. [Google Scholar] [CrossRef]
- Pelah, D.; Shoseyov, O.; Altman, A.; Bartels, D. Water-Stress Response in Aspen (Populus tremula): Differential Accumulation of Dehydrin, Sucrose Synthase, GAPDH Homologues, and Soluble Sugars. J. Plant Physiol. 1997, 151, 96–100. [Google Scholar] [CrossRef]
- Zhang, X.-H.; Rao, X.-L.; Shi, H.-T.; Li, R.-J.; Lu, Y.-T. Overexpression of a Cytosolic Glyceraldehyde-3-Phosphate Dehydrogenase Gene OsGAPC3 Confers Salt Tolerance in Rice. Plant Cell Tiss Organ Cult. 2011, 107, 1–11. [Google Scholar] [CrossRef]
- Miao, L.; Chen, C.; Yao, L.; Tran, J.; Zhang, H. Genome-Wide Identification, Characterization, Interaction Network and Expression Profile of GAPDH Gene Family in Sweet Orange (Citrus sinensis). PeerJ 2019, 7, e7934. [Google Scholar] [CrossRef]
- Stracquadanio, G.; Umeton, R.; Papini, A.; Liò, P.; Nicosia, G. Analysis and Optimization of C3 Photosynthetic Carbon Metabolism. In Proceedings of the 2010 IEEE International Conference on BioInformatics and BioEngineering, Philadelphia, PA, USA, 31 May–3 June 2010; IEEE: Philadelphia, PA, USA, 2010; pp. 44–51. [Google Scholar]
- Begum, N.; Wang, L.; Ahmad, H.; Akhtar, K.; Roy, R.; Khan, M.I.; Zhao, T. Co-Inoculation of Arbuscular Mycorrhizal Fungi and the Plant Growth-Promoting Rhizobacteria Improve Growth and Photosynthesis in Tobacco Under Drought Stress by Up-Regulating Antioxidant and Mineral Nutrition Metabolism. Microb. Ecol. 2022, 83, 971–988. [Google Scholar] [CrossRef]
- Gowtham, H.G.; Singh, S.B.; Shilpa, N.; Aiyaz, M.; Nataraj, K.; Udayashankar, A.C.; Amruthesh, K.N.; Murali, M.; Poczai, P.; Gafur, A.; et al. Insight into Recent Progress and Perspectives in Improvement of Antioxidant Machinery upon PGPR Augmentation in Plants under Drought Stress: A Review. Antioxidants 2022, 11, 1763. [Google Scholar] [CrossRef] [PubMed]
- Mufti, R.; Bano, A. PGPR-Induced Defense Responses in the Soybean Plant against Charcoal Rot Disease. Eur. J. Plant Pathol. 2019, 155, 983–1000. [Google Scholar] [CrossRef]
- Basra, S.M.A.; Farooq, M.; Tabassam, R.; Ahmad, N. Physiological and Biochemical Aspects of Pre-Sowing Seed Treatments in Fine Rice (Oryza sativa L.). Seed Sci. Technol. 2005, 33, 623–628. [Google Scholar] [CrossRef]
- Warwate, S.; Kandoliya, U.K.; Bhadja, N.V.; Golakiya, B.A. The Effect of Seed Priming with Plant Growth Promoting Rhizobacteria (PGPR) on Growth of Coriander (Coriandrum sativum L.) Seedling. Int. J. Curr. Microbiol. Appl. Sci. 2017, 6, 1926–1934. [Google Scholar] [CrossRef]
- Agbodjato, N.A.; Noumavo, P.A.; Adjanohoun, A.; Agbessi, L.; Baba-Moussa, L. Synergistic Effects of Plant Growth Promoting Rhizobacteria and Chitosan on In Vitro Seeds Germination, Greenhouse Growth, and Nutrient Uptake of Maize (Zea mays L.). Biotechnol. Res. Int. 2016, 2016, 7830182. [Google Scholar] [CrossRef]

| Number | Nomenclature | Number | Nomenclature |
|---|---|---|---|
| R17 | Agrobacterium radiobacter | F3-3-1 | Bacillus altitudinis |
| R111 | Pseudochrobactrum asaccharolyticum | R335 | Bacillus aryabhattai |
| R328 | Pseudomonas mediterranea | R33A | Bacillus cereus |
| R73 | Pseudomonas asiatica | R43 | Bacillus flexus |
| R27 | Pseudomonas composti | R65A | Bacillus halotolerans |
| R219 | Pseudomonas corrugata | R25 | Bacillus tequilensis |
| R322A | Pseudomonas mendocina | R71B1 | Bacillus wiedmannii |
| R74 | Pseudomonas stutzeri | R32 | Paenibacillus dongdonensis |
| R77 | Pseudomonas zhaodongensis | R713 | Microbacterium aerolatum |
| R317 | Advenella kashmirensis subsp. methylica | R210 | Microbacterium esteraromaticum |
| R511 | Alcaligenes faecalis subsp. phenolicus | R24 | Microbacterium oxydans |
| R75 | Bosea thiooxidans | R72A | Microbacterium shaanxiense |
| F1-2 | Brucella cytisi | R41 | Arthrobacter pokkalii |
| R54 | Proteus mirabilis | R37 | Brevibacterium sediminis |
| R62 | Providencia vermicola | R115 | Leucobacter aridicollis |
| R217 | Sphingobacterium mizutaii | R110 | Leucobacter iarius |
| R325 | Empedobacter brevis | F4-1 | Rhodococcus biphenylivorans |
| R112A | Myroides odoratimimus subsp. xuanwuensis | R336 | Rhodococcus sovatensis |
| Number | OD600 | IAA Production (μg·mL−1) | Number | OD600 | IAA Production (μg·mL−1) |
|---|---|---|---|---|---|
| F1-2 | 0.061 | 1.60 | R75 | 0.060 | 1.54 |
| F2-3 | 0.071 | 2.20 | R77 | 0.088 | 3.22 |
| F3-3-1 | 0.079 | 2.69 | R79 | 0.070 | 2.14 |
| F4-1 | 0.065 | 1.84 | R110 | 0.077 | 2.57 |
| F8-5 | 0.069 | 2.08 | R111 | 0.069 | 2.08 |
| R17 | 0.067 | 1.96 | R112A | 0.071 | 2.20 |
| R23 | 0.083 | 2.93 | R112B | 0.079 | 2.69 |
| R24 | 0.068 | 2.02 | R115 | 0.069 | 2.08 |
| R25 | 0.108 | 4.43 | R118 | 0.078 | 2.63 |
| R27 | 0.098 | 3.83 | R210 | 0.080 | 2.75 |
| R32 | 0.075 | 2.45 | R217 | 0.065 | 1.84 |
| R33A | 0.086 | 3.11 | R219 | 0.090 | 3.35 |
| R37 | 0.089 | 3.29 | R312 | 0.061 | 1.60 |
| R41 | 0.070 | 2.14 | R312B | 0.075 | 2.45 |
| R42 | 0.065 | 1.84 | R317 | 0.199 | 9.92 |
| R43 | 0.067 | 1.96 | R320 | 0.072 | 2.27 |
| R54 | 0.100 | 3.95 | R322A | 0.076 | 2.51 |
| R62 | 0.159 | 7.51 | R325 | 0.067 | 1.96 |
| R65A | 0.073 | 2.33 | R328 | 0.080 | 2.75 |
| R71B1 | 0.066 | 1.90 | R335 | 0.070 | 2.14 |
| R71B2 | 0.084 | 2.99 | R336 | 0.070 | 2.14 |
| R72A | 0.072 | 2.27 | R510 | 0.066 | 1.90 |
| R73 | 0.080 | 2.75 | R511 | 0.068 | 2.02 |
| R74 | 0.070 | 2.14 | R713 | 0.067 | 1.96 |
| Number | D (cm) | d (cm) | D/d | Number | D (cm) | d (cm) | D/d |
|---|---|---|---|---|---|---|---|
| R118 | 1.20 | 0.50 | 2.40 | R77 | 0.90 | 0.65 | 1.38 |
| R17 | 0.85 | 0.35 | 2.43 | R65A | 1.20 | 0.55 | 2.18 |
| R111 | 0.80 | 0.35 | 2.29 | R511 | 0.70 | 0.55 | 1.27 |
| R24 | 1.30 | 0.65 | 2.00 | R41 | 0.90 | 0.30 | 3.00 |
| R23 | 0.70 | 0.45 | 1.56 | R43 | 1.00 | 0.50 | 2.00 |
| R25 | 0.90 | 0.40 | 2.25 | R62 | 0.60 | 0.40 | 1.50 |
| R210 | 1.30 | 0.85 | 1.53 | R322A | 1.30 | 1.10 | 1.18 |
| F1-2 | 0.90 | 0.60 | 1.50 | R219 | 1.00 | 0.30 | 3.33 |
| F3-3-1 | 1.60 | 0.95 | 1.68 | R328 | 1.10 | 0.55 | 2.00 |
| R32 | 1.50 | 0.85 | 1.77 | R335 | 1.20 | 0.65 | 1.85 |
| R317 | 0.40 | 0.15 | 2.67 | R33A | 1.00 | 0.50 | 2.00 |
| Number | OD680 | Number | OD680 |
|---|---|---|---|
| R325 | 3.1275 | R112B | 2.1290 |
| R25 | 3.0795 | R322A | 2.1045 |
| F4-1 | 3.0620 | R75 | 2.0435 |
| R62 | 3.0220 | R511 | 2.0410 |
| R336 | 3.0205 | R54 | 2.0245 |
| R17 | 3.0010 | R219 | 1.8840 |
| R317 | 2.8160 | R71B1 | 1.8315 |
| R110 | 2.7540 | F3-3-1 | 1.6190 |
| R27 | 2.2120 | R713 | 1.5740 |
| R65A | 2.1370 | R77 | 1.4970 |
Disclaimer/Publisher’s Note: The statements, opinions and data contained in all publications are solely those of the individual author(s) and contributor(s) and not of MDPI and/or the editor(s). MDPI and/or the editor(s) disclaim responsibility for any injury to people or property resulting from any ideas, methods, instructions or products referred to in the content. |
© 2023 by the authors. Licensee MDPI, Basel, Switzerland. This article is an open access article distributed under the terms and conditions of the Creative Commons Attribution (CC BY) license (https://creativecommons.org/licenses/by/4.0/).
Share and Cite
Zhao, Y.; Hong, Y.; Wang, P.; Gou, Y.; Zeng, R.; Zhang, Q.; Chen, D.; Song, Y. Assembly of Tomato Rhizobacteria from Different Functional Groups Improves Seedling Photosynthesis and Growth. Plants 2023, 12, 4000. https://doi.org/10.3390/plants12234000
Zhao Y, Hong Y, Wang P, Gou Y, Zeng R, Zhang Q, Chen D, Song Y. Assembly of Tomato Rhizobacteria from Different Functional Groups Improves Seedling Photosynthesis and Growth. Plants. 2023; 12(23):4000. https://doi.org/10.3390/plants12234000
Chicago/Turabian StyleZhao, Yi, Yingqi Hong, Peng Wang, Yirong Gou, Rensen Zeng, Qianrong Zhang, Dongmei Chen, and Yuanyuan Song. 2023. "Assembly of Tomato Rhizobacteria from Different Functional Groups Improves Seedling Photosynthesis and Growth" Plants 12, no. 23: 4000. https://doi.org/10.3390/plants12234000
APA StyleZhao, Y., Hong, Y., Wang, P., Gou, Y., Zeng, R., Zhang, Q., Chen, D., & Song, Y. (2023). Assembly of Tomato Rhizobacteria from Different Functional Groups Improves Seedling Photosynthesis and Growth. Plants, 12(23), 4000. https://doi.org/10.3390/plants12234000

